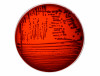

eazyplex® SuperBug CRE is a qualitative in vitro diagnostic medical device for the detection of bacteria that are capable, from a genetic stand-point, of producing carbapenemases of various types. This is achieved via the detection of specific nucleic acid sequences (DNA) from rectal swabs, urine, bacterial colonies or positive blood culture bottles.
eazyplex® SuperBug CRE detects all the described variants of metallo-ß-lactamases of the VIM-, NDM, KPC-type, as well as the OXA-48 family and OXA-181. In addition, ESBL, of the CTX-M-1-group and the CTX-M-9-group can be detected. The test is first performed manually (test preparation) and then automatically in combination with a Genie II MK2 or Genie HT device (amplification process and measurement)
The intended purposes of the test include:
- Screening of asymptomatic patients via rectal swabs or urine samples.
- Diagnosis (confirmatory assay to verify results of previous testing) and aid to diagnosis (providing additional information to assist in the determination or verification of a patient's clinical status, wherein the test is not the sole determinant) of all kinds of patients via testing bacterial colonies or positive blood culture bottles.
Protective mechanisms preventing the use of false results:
- Performance of a "inhibition control" with each sample prevents the use of false negative test results due to the inhibition of the amplification reaction, whilst simultaneously serving as reagent control.
- The test result is only displayed if the inhibition control is valid.
- As required, a test strip can be processed as negative/ contamination control by testing RALF without addition of sample material. In this case, only the inhibition control is allowed to create a positive signal.